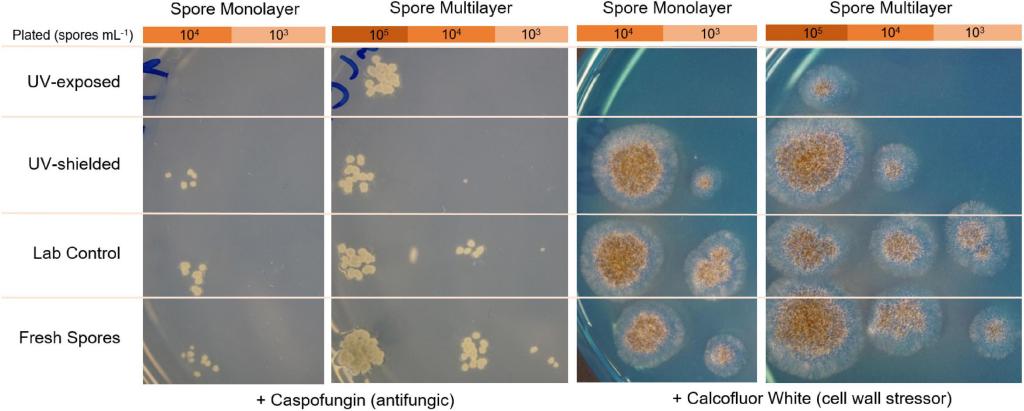

Разбираем мир микробиологии по кусочкам
Планета Марс в коробке – микробы выжили в марсианских условиях
В 1964 году произошла успешная миссия запуска космического аппарата Mariner IV на Марс, которая подарила миру первые снимки крупным планом с поверхности красной планеты. В течение следующих пятидесяти лет ученые продолжали исследовать эту планету, и смогли успешно приземлить несколько марсоходов для более подробного изучения. Находящиеся на Марсе аппараты Curiosity и Opportunity (Opportunity на данный момент является не активным) ищут доказательства признаков жизни (химические строительные блоки, биосигнатуры) и воды.
18 февраля 2021 года новый марсоход под названием Perseverance совершил свою первую посадку на Марс. Одна из целей этой экспедиции – узнать, может ли марсианская среда поддерживать любую форму жизни, и найти новые доказательства существования в этой среде признаков прежней микробной жизни!

На данный момент исследователи сделали вывод, что природная среда Марса не очень дружелюбна. Она На данный момент исследователи сделали вывод, что природная среда Марса не очень дружелюбна. Она характеризуется повышенной сухостью воздуха с чрезвычайно низкой температурой и давлением. Более того, из-за отсутствия прочной атмосферы (атмосфера Марса состоит из газа), поверхность планеты постоянно находится под ультрафиолетовыми, рентгеновскими или гамма излучениями. С земной точки зрения, поверхность Марса кажется довольно биоцидной и не пригодной для жизни…
Зачем же тогда ученым выяснять, переживут ли наши земные микробы космические путешествия и, более того, смогут ли они расти на Марсе? С повышенным вниманием к миссия по исследованию Марса, микробы могут стать незаменимыми компаньонами в колонизации этой планеты, потому что они смогут помочь с производством продуктов питания и материалов в независимости от нахождения на Земле. Примером этого может служить использование грибкового мицелия для замены пены, древесины, полов и мебели. Не стоит забывать, что в человеческом организме также присутствует большое количество микроорганизмов, и исследователям нужно выяснить смогут ли эти микроорганизмы выжить в неземной среде, поскольку некоторые из них могут представлять опасность для здоровья космонавтов.
В недавнем исследовании, проведенном Мартой Кортесао и ее коллегами, четыре микроорганизма были проверены на их выживаемость в марсианских условиях. Исследования такого типа проводятся на Земле с имитацией марсианских условий среды, где засуха, экстремальные температуры и повышенная радиация являются основными факторами тестирования.
Похожую среду можно найти высоко над поверхностью Земли в стратосфере (примерно на 15-50 км над уровнем моря). Такая среда может быть даже больше похожа на то, что находится на Марсе, по сравнению с марсианской средой созданной на Земле в лаборатории: интенсивное УФ-излучение, ионизирующее излучение высокой энергии, высокий уровень сухости воздуха, гипоксия (низкий уровень кислорода), сверхнизкие температуры, и низкое давление. Именно в таких условиях и был проведен этот эксперимент.

Изображение было взято из исследования (figure from original article).
Используя аэростат, авторы отправили MARSBOx на высоту ~ 38 км на семь часов. Они изучили уровень выживаемости и метаболизма четырех микроорганизмов в условиях радиации и других факторов окружающей среды.
В ходе эксперимента были использованы два вида экстремофилов (Salinisphaera shabanensis и Buttiauxella sp.), чтобы проверить гипотезу о том, что виды, обитающие в экстремальных условиях аналогичных Марсу на Земле, смогут адаптироваться к условиям Марса. S. shabanensis обитает в среде с чрезвычайно высоким уровнем соли на глубине 1,3 км от уровня моря. Buttiauxella sp. обитает в сульфидных (состоящих из серы) рудниках с дефицитом кислорода и ограниченными питательными веществами.
Также, в исследовании были протестированы такие микроорганизмы, как Aspergillus niger (грибок) и бактерия Staphylococcus capitis, поскольку они являются патогенными микроорганизмами. Эти два организма уже ранее были обнаружены внутри Международной Космической Станции (МКС) и, вероятно, отправятся на Марс в ходе следующих космических миссий.

Выживание микроорганизмов после эксперимента
Вид Buttiauxella sp. не смог выжить ни в лабораторных условиях, ни в полетных образцах MARSBOх. Остальные три вида выжили и были протестированы в нескольких условиях:
- Лабораторные условия (5 месяцев в условиях засухи);
- В нижнем отсеке аппарата MARSBOx, где образцы были защищены от радиации;
- В верхнем отсеке аппарата, где образцы получили дозу радиации, схожую с той что на Марсе.
Чтобы протестировать количество радиации нужное для уничтожения спор грибка A.niger, споры были пророщены в один слой или наложены друг на друга, чтобы создать эффект многослойности.


Изображение В: S.shabanensis
Изображение С: A.niger (один слой спор)
Изображение D: A.niger (несколько слоев спор)
На основе результатов исследования была создана диаграмма, показывающая количество клеток бактерий и спор грибков выживших в суровых условиях. Оба вида бактерий показали высокую чувствительность к радиации. Только 1/1,000,000 клеток вида S.shabanensis смогла прорасти, а клетки бактерии S.capitis не проросли вообще. Споры грибка A.niger были устойчивы ко всем условиям: как минимум 1/100 спор смогла выжить!
Тестирование стенок клетки на переносимость стресса
Авторы исследования также изучили устойчивость клеточной стенки грибка A.niger к стрессу. “Стрессовым” факторами для роста грибка были два реагента: противогрибковое средство Каспофунгин и Калькофлюр белый, который нарушает структуру клеточной стенки. Как показано на рисунке ниже, споры, которые не были подвергнуты ультрафиолетовому излучению, демонстрируют пониженную способность справляться со стрессом, если этот стресс был направлен на клеточную стенку. Также результаты показали, что споры, подвергнутые воздействию ультрафиолета, были очень чувствительны к радиации и росли только тогда, когда большое количество спор было первоначально помещено для выращивания (эффект многослойности).
В заключении, три из четырех видов микроорганизмов смогли успешно “пережить” путешествие на Марс! На короткое время они могли перенести суровые условия стратосферы, и потенциально выжили бы на поверхности Марса. Это исследование дает представление о том, какие микробы могут выжить в среде обитания, которая обычно считается «смертельной».
Этот эксперимент является только началом, поскольку исследователи еще не знают, какие природные механизмы были использованы бактериями для выживания. Одна из гипотез выживания грибка A.niger заключается в том, что его споры имеют «солнцезащитную пигментацию» – определенную клеточную структуру, которая защищает от радиации. Будущие исследования могут помочь ученым определить, почему эти микробы выжили и какие механизмы они использовали.
Следующая миссия MARSBOx уже имеет запланированный маршрут: аппарат полетит в стратосферу из Антарктики, где солнечное излучение и космические лучи еще больше имитируют условия на Марсе. С повышенным вниманием к исследованию поверхности Марса, потребность в дополнительных исследованиях и поисках аналогов этой планеты будет только возрастать.

Перевод был сделан Марией Мартыновой